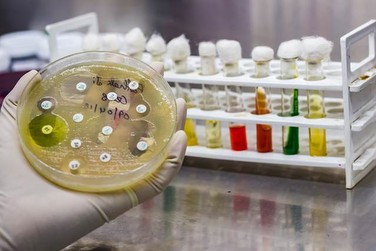

You'll receive the latest updates on new standards, guidelines, and educational resources, as well as expert insights to help enhance your laboratory's performance and compliance.
The Value of Intermediate^ or “I^”
Graeme Forrest, Rush University Medical Center, Chicago, IL
Case 1: A 75-year-old male with diabetes and chronic kidney disease with an estimated glomerular filtration rate (eGFR) of 40 ml/min presented to the clinic with onset of urinary frequency and dysuria over 2 days without any systemic symptoms. A urinalysis showed 4+ glucose, 1+ blood, many white blood cells (WBCs,) and was positive for nitrites and leukocyte esterase. A urine culture was obtained, but given the lack of systemic symptoms and pending culture results, he was not prescribed an antimicrobial agent. The culture grew >105 CFU/mL Escherichia coli with susceptibility results as shown in Table 1.
Graeme Forrest, Rush University Medical Center, Chicago, IL
Case 1: A 75-year-old male with diabetes and chronic kidney disease with an estimated glomerular filtration rate (eGFR) of 40 ml/min presented to the clinic with onset of urinary frequency and dysuria over 2 days without any systemic symptoms. A urinalysis showed 4+ glucose, 1+ blood, many white blood cells (WBCs,) and was positive for nitrites and leukocyte esterase. A urine culture was obtained, but given the lack of systemic symptoms and pending culture results, he was not prescribed an antimicrobial agent. The culture grew >105 CFU/mL Escherichia coli with susceptibility results as shown in Table 1.
Graeme Forrest, Rush University Medical Center, Chicago, IL
Case 1: A 75-year-old male with diabetes and chronic kidney disease with an estimated glomerular filtration rate (eGFR) of 40 ml/min presented to the clinic with onset of urinary frequency and dysuria over 2 days without any systemic symptoms. A urinalysis showed 4+ glucose, 1+ blood, many white blood cells (WBCs,) and was positive for nitrites and leukocyte esterase. A urine culture was obtained, but given the lack of systemic symptoms and pending culture results, he was not prescribed an antimicrobial agent. The culture grew >105 CFU/mL Escherichia coli with susceptibility results as shown in Table 1.
Table 1. Escherichia coli Results
Cefuroxime has been shown to be an effective choice for treatment of uncomplicated urinary tract infections (uUTIs) in the elderly population seen at this clinic. Although cefazolin can be tested as a surrogate for oral cephalosporins, cefazolin may overcall resistance to cefuroxime (also for cefdinir and cefpodoxime) for some isolates. Consequently, the antimicrobial stewardship team who works with this clinic requested that the laboratory report both cefazolin and cefuroxime on all urine isolates of E. coli, K. pneumoniae, and P. mirabilis.
For this particular patient, the clinician called the laboratory to ask why there was a discrepancy between the cefuroxime and cefazolin results. The laboratory indicated that the cefuroxime MIC of 16 µg/mL should be considered “I^,” meaning likely susceptible when cefuroxime is prescribed orally for isolates from uUTIs.
An optional comment can be added to the laboratory report, to help explain this discrepancy such as: “Cefuroxime concentrates in the urine. An MIC of ≤16 µg/mL indicates a high probability of clinical efficacy for treatment of uncomplicated urinary tract infections.”
This case reflects a common clinical scenario for managing uUTIs in elderly patients. Where possible, clinicians should avoid unnecessary use of the fluoroquinolones for treatment of uUTIs as the risks of tendon rupture, neurologic abnormalities, and other adverse events outweigh the value of using these agents for treating relatively mild infections. These risks are outlined in black box warnings for the fluoroquinolones in the drug label. In addition, because this patient has poor kidney function (indicated by low eGFR), some clinicians would avoid use of nitrofurantoin. The clinician prescribed cefuroxime for 5 days and the patient’s symptoms resolved within 2 days. Other oral cephalosporins (eg, cephalexin) also attain very high concentrations in the urine. Cefuroxime can be given less frequently than some of the other agents, and as such is an attractive choice for this type of case.
Case 2: After 8 days of hospitalization, a 55-year-old female with spinal cord injury and a chronic indwelling catheter developed fever, chills, and hypotension. The patient was well known to the treating team for having had prior urosepsis due to multidrug resistant Pseudomonas aeruginosa. Based on culture and susceptibility results from prior clinic visits, she was started empirically on meropenem 2 g every 8 hours and amikacin 20 mg/kg x one dose. Blood cultures were negative. Urine cultures grew >105 CFU/mL P. aeruginosa with susceptibility results as shown in Table 2.
Table 2. Pseudomonas aeruginosa Results
This patient represents a challenging clinical and laboratory case. The patient has a chronic source for Pseudomonas infection which is the indwelling catheter. Indwelling catheters are frequently colonized by bacteria, especially gram-negative rods, and antimicrobial agents should only be prescribed if there are clinical symptoms of infection. It appears this patient has an active lower urinary tract infection without bacteremia. Complicating management of this patient is the apparent lack of suitable first-line antimicrobial agents available for treatment. The source of infection and the organism’s susceptibility results can aid in selection of an antimicrobial course. Catheter replacement, with antimicrobial therapy are indicated for the management of these complex infections. As both ciprofloxacin and gentamicin concentrate in the urine, “I” in this case can be considered “I^.” Clinically, both should be efficacious for treatment of uUTIs due to P. aeruginosa. Understanding “I^” could help the clinician avoid using newer, broad-spectrum and expensive β-lactam combination agents (eg, ceftolozane-tazobactam or ceftazidime-avibactam), preserving these agents for more serious infections. The patient was prescribed intravenous ciprofloxacin 400 mg every 12 hours, with rapid resolution of fever and was discharged on oral ciprofloxacin 750 mg every 12 hours for a complete 7-day course.
In summary, the “I^” can be applied to specific antimicrobial agents administered orally or parenterally, that concentrate well in the urine. This may not be applicable for all isolates from urine and would depend on the source and extent of the infection. The intent of the “I^” is to encourage providers to use narrower-spectrum antimicrobial agents more appropriately and avoid unnecessary use (for uncomplicated cases) of newer agents. To learn more about the “I^” concept and how to communicate this concept with various stakeholders, refer to the feature article in this News Update.
This article came from AST News Update, Volume 6, Issue 1 – April 2021 which is produced by the CLSI Outreach Working Group (ORWG). The ORWG is part of the CLSI Subcommittee on Antimicrobial Susceptibility Testing (AST) and was established in 2015. The formation of the working group originated in a desire to efficiently convey information regarding contemporary AST practices, recommendations, and resources to the clinical microbiology community. They welcome suggestions from you about any aspect of CLSI documents, educational materials, or their Newsletters.